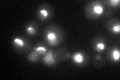
YJL010C

View description
Essential subunit of U3-containing 90S preribosome involved in production of 18S rRNA and assembly of small ribosomal subunit; also part of pre-40S ribosome and required for its export into cytoplasm; binds RNA and contains pumilio domain
Localization:
Intensity:
Fold change:
Significance:
-
C’ GFP library in SD

nucleolus71.94 -
N' NOP1pr-GFP in SD

nucleolus126.923 -
N' TEF2pr-mCherry in SD

nucleus195.895 -
N' NATIVEpr-GFP in SD

nucleus,nucleolus71.1502 -
N' TEF2pr-VC and Cyto-VN in SD

nucleus,nucleolus56.664 -
C’ GFP library in SD+DTT

nucleolus54.820.76No -
C’ GFP library in SD+H2O2
nucleolus69.080.96No -
C’ GFP library in Starvation Media

nucleolus35.380.49Yes -
C’ GFP library on the background of Pup2-DaMP

N/A -
C’ GFP library on the background of CCT mutant

N/A0N/AYes
